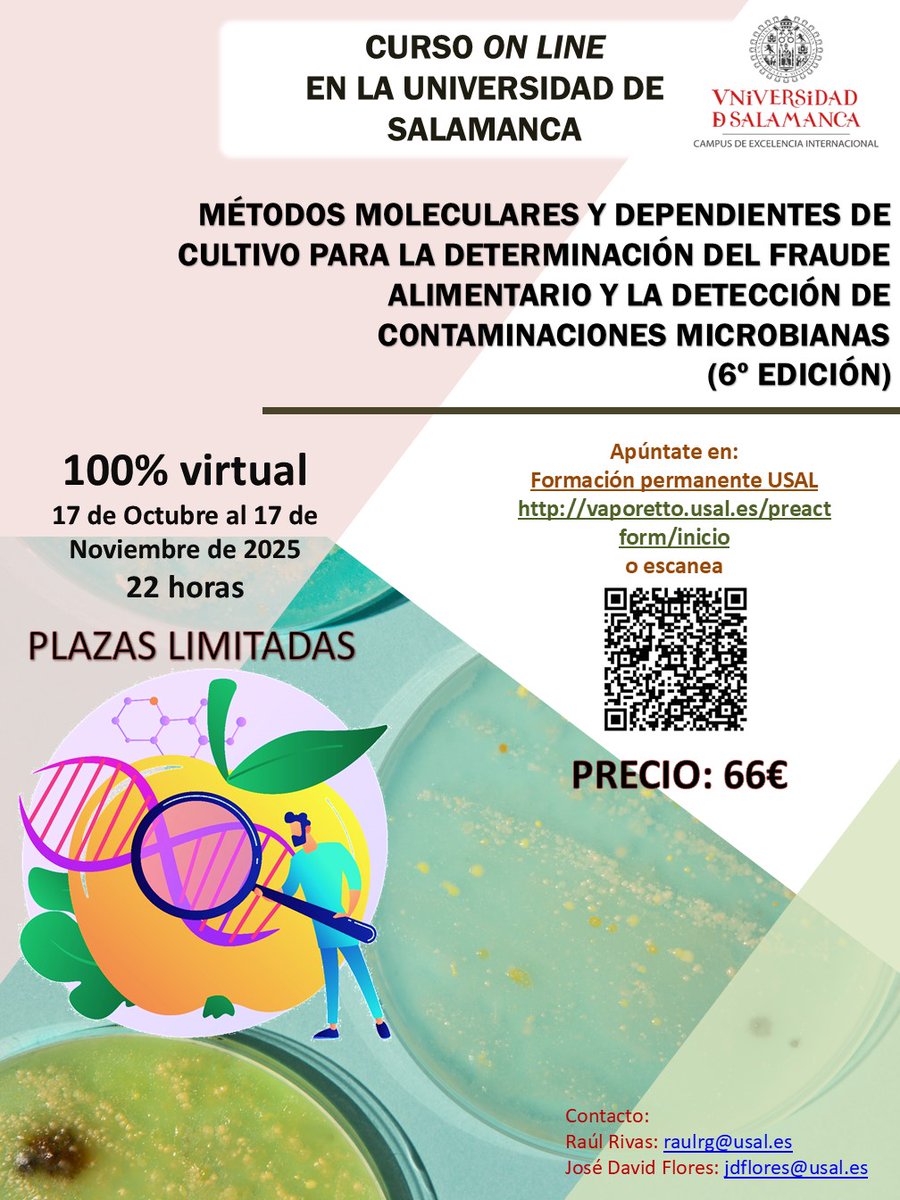
▶️Curso de formación específica.
Métodos moleculares y dependientes de cultivo para la determinación del fraude alimentario y la
detección de contaminaciones microbianas (6ª edición).
💻On-line.
📅17/10/2025 a 17/11/2025
Inscripción: vaporetto.usal.es/preactform/det…

Raúl Rivas
@raulrivasg
Catedrático de Microbiología. Director del Servicio de Producción e Innovación Digital y del GIR Interacciones Microbianas de @usal. Responsable de @UCCiUSAL
ID: 592923985
https://microusal.com 28-05-2012 17:45:50
7,7K Tweet
2,2K Followers
1,1K Following

🧪☀️ CAMPAMENTO DE VERANO DE CULTURA CIENTÍFICA Y DE LA INNOVACIÓN Hoy hemos despedido a todos nuestros niños y niñas con un taller de introducción a la robótica LEGO en Parque Científico de la Universidad de Salamanca Esperamos que hayáis disfrutado muchísimo de la experiencia. ¡Feliz verano!


🧪☀️ CAMPAMENTO DE VERANO DE CULTURA CIENTÍFICA Y DE LA INNOVACIÓN 📷 Algunas imágenes de las actividades de la segunda semana ⬇️ Cultura, costumbres y origami en Japón con Centro Cultural Hispano-Japonés Radio USAL

🏃🏽♀️🏃🏼🔬 CARRERA POR LA INVESTIGACIÓN Y LA TRANSFERENCIA 🏆 Entrega del premio al proyecto TCUE ganador: T-Balance-Prototipo para la rehabilitación del control del tronco en afecciones neuromusculares, de Equipo de Investigación en Neurorrehabilitación y ETSII_Bejar


Farmacia_USJ TevaFarmacia Universidad San Jorge Arrancamos con la ponencia inaugural de nuestro compañero Raúl Rivas González





Verano y piscinas, una combinación que aumenta el riesgo de padecer criptosporidiosis ✍️🏽Un artículo de Raúl Rivas en The Conversation ES theconversation.com/verano-y-pisci…


Verano y piscinas, una combinación que aumenta el riesgo de padecer criptosporidiosis cadenaser.com/nacional/2025/… a través de Cadena SER


¿Qué es la dermatosis nodular contagiosa qué ha obligado a modificar el recorrido del Tour de Francia? ✍️🏽Un artículo de Raúl Rivas, profesor de Universidad de Salamanca, en The Conversation ES theconversation.com/que-es-la-derm…




Por aquí os dejo nuestro último artículo publicado (Q1) en npj Journals en el que evaluamos la funcionalidad antioxidante de un bioinoculante bacteriano utilizando Caenorhabditis elegans bajo estrés oxidativo. nature.com/articles/s4153…


Muchas gracias a #DanielMartinReina por la amable reseña que ha hecho de #Superorganismos de Guadalmazanlibros Por aquí la dejo hablandodeciencia.com/resenas-hdc-su…